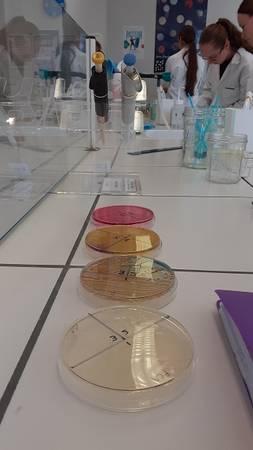

Année scolaire 2025-2026
Le Cap Métiers Tour à la cité scolaire de Nontron
Le Cap Métiers Tour est à la cité scolaire Alcide Dusolier à Nontron la semaine du 22 au 26 septembre 2025.
Le Cap Métiers Tour est un événement itinérant qui permet aux collégiens et lycéens de découvrir divers métiers et formations disponibles dans la région Nouvelle Aquitaine de manière ludique et interactive.
Dans le cadre du Parcours Avenir, les élèves de 5e s'y sont rendus mardi matin 23 septembre.

Prolongez l'expérience : Cap Métiers propose un produit de découverte des métiers exclusivement en ligne : "Le jeu des métiers" - trois questions pour trouver le code et découvrir un métier.
Année scolaire 2024-2025
Visite du lycée Alcide Dusolier de Nontron, lycée de secteur
Jeudi 20 février 2025, les élèves des classes de troisième ont été accueillis par des élèves de première professionnelle Métiers du Commerce et de la Vente qui avaient organisé la visite du Lycée général et professionnel Alcide Dusolier de NONTRON et qui avaient préparé pour cette occasion une collation (crêpes, gâteaux, ).
Madame la Proviseure, Madame Jenniches , a présenté le lycée et les différentes voies de formation à l'ensemble des élèves de 3ème. Puis, les élèves, répartis en trois groupes ont été pris en charge par des élèves de première professionnelle Métiers du Commerce et de la Vente qui les ont accompagnés dans les ateliers suivants :
Atelier 1 : Présentation du Lycée Professionnel : Découverte de la section ASSP (Accompagnement, soins et services à la personne).
Atelier 2 : Présentation du Lycée Professionnel : Découverte de la section MRC (Métiers de la Relation Client).
Atelier 3 : Visite des locaux de l'établissement y compris l'internat avec un jeu tout au long de la visite.
Les élèves ont déjeuné au réfectoire du lycée. Cette matinée fut l'occasion pour eux de se projeter dans la vie de lycéens qui les attend l'an prochain (salles de travail, organisation, internat , ...), d'échanger avec des lycéens dont de nombreux anciens élèves du collège et pour certains d'entre eux de susciter l'envie de faire un stage d'immersion en voie professionnelle dans ce lycée.
Nous remercions chaleureusement Madame Jenniches, Proviseure de l'établissement ainsi que les enseignants et lycéens pour l'organisation de cette visite.
Madame Jenniches, Proviseure de la cité scolaire Alcide Dusolier, viendra spécialement au collège Vendredi 21 mars à 17h30 à lauditorium pour présenter les formations et létablissement aux parents dont la présence est vivement souhaitable.
Madame Mouret, professeur de SVT.
Cordées de la réussite : intervention de l'École Nationale de la Magistrature
Dans le cadre des Cordées de la réussite avec lÉcole Nationale de la Magistrature et la Clinique du droit à Bordeaux, une intervention « Objectif Droits » a eu lieu vendredi 7 février 2025.
Trois étudiants en Master 1 de droit «enjeux et techniques de droit social» sont intervenus auprès des deux classes de 4èmeet des deux classes de 3ème sur les thèmes de la protection de lenfance et des droits des enfants.
Ils ont présenté :
- les cinq droits de l'enfant (identité, santé, éducation, protection et participation) avec une activité sous forme de mots croisés.
- les quatre types de violences (physiques, psychologiques, sexuelles et négligences) avec une activité en petits groupes au cours de laquelle les élèves ont pu placer sept situations concrètes sur l' échelle d'un violentomètre.
- les numéros utiles (ex: le 119) et les ressources disponibles.
- la procédure de signalement et ses suites.
- les acteurs administratifs de la protection de l'enfance (le président du Conseil départemental et l' ASE) et les acteurs judiciaires (juge et avocat des enfants, PJJ, administrateur ad hoc) ainsi que les structures de placement (familles d'accueil, MECS, foyers de l'enfance).
- les métiers en lien avec la protection de l'enfance dans le secteur social (assistant social, assistant familial), le secteur médical (psychologue, infirmier scolaire), le secteur juridique (juge des enfants, avocat pour enfants, ...) ou bien la Protection Judiciaire de la Jeunesse (éducateur, directeur de service).
Cordées de la réussite : visite du lycée Jay de Beaufort
Dans le cadre des "Cordées de la réussite", les élèves des classes de 3ème A et 3ème B ont participé à une sortie scolaire au lycée Jay de Beaufort à Périgueux, le jeudi 6 février 2025 de 8h30 à 13h30.
Suite à une présentation du dispositif, les étudiants de BTS SP3S (services et prestations des secteurs sanitaire et social, bac +2) et DTS IMRT (imagerie médicale et radiologie thérapeutique, bac +3) ont présenté leurs formations et leurs parcours d'études.
Ensuite, les élèves ont pu participer à des ateliers de découverte des séries technologiques STL (atelier « Biotechnologies ») ou ST2S (atelier « Chimie Biologie physiopathologie », atelier « Sciences et technologies sanitaires et sociales ») accompagnés par des élèves en Terminale technologique.
Les élèves ont déjeuné au réfectoire du lycée puis ont visité l'établissement (internat, etc ...) accompagnés par des élèves de Première technologique avant de terminer par un temps d'échanges pour faire le bilan de la matinée.
Cette sortie a pour objectifs de montrer aux élèves la diversité des parcours, les passerelles possibles, l'importance de la mobilité géographique et de découvrir des filières technologiques envisageables après la classe de 2nde GT.
Elles bougent pour l'orientation

Dans le cadre du Parcours Avenir en lien avec l'orientation, les élèves filles des classes de 4ème et 3ème ont participé à la 4ème édition de l'opération "Elles bougent pour l'orientation" le mardi 3 décembre de 10h40 à 12h30.
Cet évènement a pour objectif de promouvoir l'ingénierie et les métiers techniques auprès des jeunes filles de France métropolitaine, d'outre-mer et à l'international dans les collèges et les lycées. Ce sont des interventions en classe avec des témoignages de femmes et d'hommes pour promouvoir les carrières scientifiques et techniques auprès des collègiennes et lycéennes.
Une marraine de l'opération, Mme Heyd (ingénieure en informatique dans l' entreprise Stryker, l'une des principales entreprises de technologie médicale au monde, à Cestas) était présente ainsi que M. Grandchamp (RSE).
Dans un premier temps, Madame Heyd a présenté son parcours d'études. Après un bac général série Scientifique, elle a suivi des études en informatique : un BUT informatique (elles étaient 10 femmes sur 100 étudiants), un Master informatique (Erasmus en Allemagne) puis un Doctorat en informatique (thèse). Mme Heyd a expliqué aux élèves qu'elle n'était pas mathématicienne mais très logique.
Puis, elle a présenté son métier. Elle est ingénieure, chef de projets informatiques dans la société américaine Stryker à Cestas (33) depuis 25 ans. Cette entreprise fabrique des implants pour la colonne vertébrale par exemple en titane que Mme Heyd avait apportés. Son travail consiste à recueillir des besoins, développer différents process, réaliser des tests, etc ... Elle travaille sur des logiciels au sein d'une équipe de 5 personnes dont elle est la seule femme.
Madame Heyd a également présenté différents métiers dans l'informatique et des femmes pionnières dans ce domaine comme par exemple Hedy Lamarr qui a inventé le Wifi.
Un temps d'échanges a permis aux élèves de poser des questions sur la formation et le métier mais aussi sur le sexisme.

Monsieur Granchamp, impliqué dans la démarche de Responsabilité sociétale des entreprises (qui désigne la contribution des entreprises aux enjeux du développement durable et dans laquelles s'inscrit l'égalité homme/femme) a présenté son parcours : études et différents postes occupés notamment dans des entreprises du bâtiment et des Travaux publics. Membre du Club Entreprises du Haut Périgord, il précise que dans le secteur, de nombreuses femmes sont entrepreneurs. Ayant travaillé à l'international, il a rappelé l'importance de la maîtrise de l'anglais.
A partir d'une photographie, il a fait réfléchir les élèves qui ont constaté qu'au sein d'une entreprise, il y a des individus des deux sexes, d'origines et d'âges différents, pouvant être porteurs de handicaps... C'est cette diversité qui constitue la richesse de l'entreprise.

Tout au long de son intervention, M. Grandchamp n'a eu de cesse d'affirmer "la supériorité des filles" (plus nombreuses à obtenir le bac et à devenir ingénieur), leur efficacité et leur réactivité qui sont des atouts pour une entreprise. Il les a donc fait réfléchir sur les causes de l'inégalité salariale entre les hommes et les femmes, sur leur plus grande difficulté à accéder aux postes de responsabilité. La maternité et l'inégale répartition des tâches au sein d'un couple sont ressorties comme les causes principales.
Il leur a adressé un discours offensif, les encourageant à être ambitieuses et à ne "pas se mettre de barrières" dans le choix de leur orientation.
5e édition du Forum Métiers Emploi Travail
Dans le cadre du parcours Avenir, les élèves de 3ème A et de 3ème B ont participé à la 5ème édition du forum Métiers Emploi Travail jeudi 17 octobre de 9h à 11h au gymnase René Forestier à Thiviers.
Ce forum a pour but de faire découvrir les métiers, formations et savoir-faire existants sur le territoire notamment par le geste.
Consultez le livret préparatoire à la visite (secteurs d'activités présents, exemples de questions, ...) qui a été présenté aux élèves en classe.
𝗗𝗲́𝗰𝗼𝘂𝘃𝗿𝗲𝘇 𝗲𝗻 𝘃𝗶𝗱𝗲́𝗼 𝘂𝗻𝗲 𝗽𝗮𝗿𝘁𝗶𝗲 𝗱𝗲𝘀 𝘀𝗲𝗰𝘁𝗲𝘂𝗿𝘀 𝗱'𝗮𝗰𝘁𝗶𝘃𝗶𝘁𝗲́𝘀 𝗽𝗿𝗲́𝘀𝗲𝗻𝘁𝘀 𝗮𝘂 𝗙𝗢𝗥𝗨𝗠 ![]() https://youtu.be/t7WM1lbtTjE
https://youtu.be/t7WM1lbtTjE
De 11h à 12h, les élèves en ont profité pour visiter le lycée professionnel Porte d'Aquitaine afin de découvrir les formations qui y sont proposées (pôle bois, pôle cuir).
22ème édition des Coulisses du Bâtiment
A l'occasion de la 22ème édition des Coulisses du Bâtiment organisée par la Fédération Française du Bâtiment, plus de 250 chantiers ateliers et CFA ont ouvert leurs portes aux scolaires dans toute la France les 10 et 11 octobre 2024.
Les élèves de 5e ont pu ainsi visiter le chantier du Centre événementiel de Bergerac. Ce centre offrira une grande salle de spectacle modulable pouvant recevoir jusqu'à 2000 personnes et pourra aussi accueillir des manifestations sportives, des salons et conférences. Un deuxième espace contiendra des salles de réunions de différentes capacités.
Cet événement permet de découvrir le monde du bâtiment, de rencontrer et voir travailler des professionnels et d'en savoir plus sur la grande diversité des métiers de ce secteur. Les élèves ont pu toucher du doigt la réalité de ces métiers par le biais d'ateliers pratiques. Une sortie apparemment appréciée par nos élèves.
Année scolaire 2023-2024
Présentation des formations du Lycée Professionnel Léonard de Vinci
Deux membres de l'équipe pédagogique du lycée professionnel Léonard de Vinci de Périgueux sont intervenus mardi 30 avril auprès des deux classes de 3ème pour leur présenter les formations de l'établissement.
Ce lycée propose 5 Bac Pro et 2 CAP :
- Bac Pro MELEC (Métiers de l'ELectricité et de ses Environnements Connectés).
- Bac Pro TRPM (Technicien en Réalisation de Produits Mécaniques).
- Bac Pro TCI (Technicien en Chaudronnerie Industrielle).
- Bac Pro HPS (Hygiène, Propreté, Stérilisation).
- Bac Pro MMV (Métiers de la Mode et du Vêtement).
- CAP Electricien
- CAP PSR (Production et Service en Restauration).
Ces formations professionnelles se font sous statut scolaire (PFMP: périodes de formation en milieu professionnel) mais pour certains élèves elles peuvent être réalisées en apprentissage à partir de la classe de 1ère pour le Bac Pro ou bien dès la première année pour le CAP. Le lycée dispose également d'une 3ème prépa-métiers (suite à la classe de 4ème).
Le lycée propose des échanges à l'étranger avec le dispositif Erasmus, d'une section sportive "Golf" et de nombreux partenariats (Marine Nationale, Vinci, Enedis, ...).
Le lycée bénéficie du label "Lycée des métiers des énergies, des productions et des mobilités en transition".
Il est encore possible d'effectuer un mini-stage cette année. Les familles des élèves intéressés doivent contacter l'établissement ou bien remplir le formulaire en ligne.
Rencontre avec 4 étudiantes de la Clinique du droit de Bordeaux
Jeudi 4 avril, quatre étudiantes en master de Criminologie à la Clinique du droit de Bordeaux sont venues à la rencontre des élèves de 3e. Un premier rendez-vous avait eu lieu l'année dernière sur le thème du droit à l'image. Cette année, le sujet de leur intervention était le harcèlement et le droit.
Après une présentation de leur parcours et de leur projet professionnel, elles ont précisé le contenu de leur formation actuelle : droit pénal, procédure pénale et criminologie, droit des mineurs qu'ils soient victimes ou auteurs.
L'intervention a consisté à étudier ce que dit le législateur sur le sujet du harcèlement. Les différents types de harcèlement ont été abordés (au travail, conjugal, scolaire, cyberharcèlement, sexuel...) et à chaque fois, les peines maximales encourues ont été annoncées. Peine qui dépend du résultat, des conséquences sur la victime. L'occasion de préciser que le harcèlement dans le cadre scolaire est puni plus sévèrement que le harcèlement en général et que le cyberharcèlement constitue une circonstance aggravante. Il est utile de savoir que la prescription pour faits de harcèlement est de 10 ans à partir du moment où la victime a 18 ans et que des poursuites peuvent avoir lieu même si la victime ne porte pas plainte. L'État dont les buts sont de maintenir l'ordre public et de permettre la sécurité des personnes peut engager les poursuites.
Une intervention qui a permis de se rendre compte que le harcèlement peut intervenir dans toutes les situations de la vie et qui est venue compléter celle du gendarme Priscilla VERDU de la Maison de Protection des Familles de Dordogne qui avait eu lieu le lundi 25 mars. Cette intervention avait permis de préciser notamment que la gendarmerie pouvait très facilement remonter et retrouver l'identité de ceux qui se cachent derrière un pseudo.
Dans un deuxième temps, les élèves, mis en situation ont été les acteurs d'un procès fictif. Après avoir listé les membres d'un procès (juge, prévenu, victime, avocats, procureur, greffier, témoins et experts) et rappelé l'ordre des prises de parole de chacun (toujours le même), les élèves ont été répartis en trois groupes : la partie civile, le procureur (avocat de la société), l'accusé. A partir d'un dossier (celui d'une élève victime de harcèlement) et aidée par les étudiantes, chacune des parties s'est lancée dans la préparation d'une plaidoierie.
Un exercice pleinement réussi aux dires des intervenantes !
Visite du lycée Albert Claveille
Après les élèves de 4ème, ce sont les élèves de 3ème qui ont été accueillis, vendredi 9 février par le lycée Albert Claveille de Périgueux afin d'en apprendre davantage sur les différentes voies proposées par l'établissement, et plus précisément les formations STI2D (Sciences et Technologies de l'Industrie et du Développement Durable), STD2A (Sciences et Technologies du Design et des Arts Appliqués), Maintenance des véhicules et SI (Sciences de l'Ingénieur).
Les élèves ont découvert les locaux du lycée : le gymnase, l'internat, la cafétéria, le CDI, la salle de mécanique, les salles de sciences, le fameux ClavFab (salle de fabrique)...
L'escale au CDI a été également l'occasion de rencontrer Valérie Galli, ancienne épéiste devenue artiste peintre qui exposait ses uvres dans l'enceinte du lycée avant de les exposer à Paris pendant les Jeux Olympiques.
La visite s'est terminée en compagnie de Fabien Auvray et Laurine Lousteaud, deux anciens élèves du collège, qui ont eu la sympathie de témoigner de leur expérience auprès de nos élèves.
Tout cela a été rondement mené par monsieur Loseille, Directeur Délégué aux Formations Professionnelles et Technologiques du lycée Claveille, que nous remercions profondément pour son investissement et sa patience.
Cordées de la réussite : rencontres au lycée Jay de Beaufort
Dans le cadre des "Cordées de la réussite", les élèves de 3ème ont participé à une sortie scolaire au lycée Jay de Beaufort à Périgueux, le mardi 6 février 2024.
Au delà de la visite du lycée, nos élèves ont participé à des ateliers scientifiques encadrés par des premières et des terminales technologiques et ont rencontré des étudiants de BTS et de DTS (bac +2) qui ont témoigné de leurs différents parcours.
Enfin, une réflexion a eu lieu autour d'un fiche de travail afin que nos collégiens puissent bénéficier d'un tutorat par un étudiant.
Coup de projecteur sur les métiers de l'industrie
En se rendant au lycée Albert Claveille jeudi matin 25 janvier, les élèves de 4e ont été sensibilisés aux métiers de l'industrie. Tout d'abord en visitant et découvrant les différents BTS proposés par l'établissement et en participant aux ateliers de l'exposition modulaire "Coup de projecteur sur les métiers de l'industrie" fruit de la collaboration de Cap Métiers Nouvelle-Aquitaine avec l'Union des Industries et des Métiers de la Métallurgie.
Exposition de Photos industrielles
Dans le cadre de Territoire d'Industrie Dordogne/Haute-Vienne, une exposition de photos industrielles a été réalisée. Du 08 au 19 janvier, le collège accueillera l'exposition "De la matière au produit fini". Celle-ci a pour but de mettre en avant les industries implantées sur le territoire des communautés de communes Périgord Nontronnais, Dronne et Belle, Pays de Saint Aulaye et Briance Sud Haute-Vienne et pour ambition de montrer la diversité de l'industrie et ses savoir-faire. Une exposition qui valorise l'image de l'industrie, indispensable, vectrice d'emplois, de carrières et de dynamisation des territoires. Douze entreprises ont participé au projet.
Sortie à l'École Nationale de la Magistrature

Dans le cadre des "Cordées de la réussite", les élèves des deux classes de 4e ont participé à une sortie scolaire à lÉcole Nationale de la Magistrature à Bordeaux le Vendredi 8 décembre 2023 (de 10h30 à 16h30).
Programme de la journée:
- Matinée: Présentation des métiers de la magistrature et des parcours des étudiants puis visite des établissements partenaires pour une présentation des métiers (droit, notariat, ...) et des parcours des étudiants. Tous ces moments pourront être suivis déchanges.
- Après-midi: Destination le Tribunal Judiciaire de Bordeaux qui jouxte l'École Nationale de la Magistrature pour participer à une audience de comparutions immédiates (une audience pour chacune des classes). Puis, retour à lÉcole Nationale de la Magistrature pour un petit moment de débrief et déchanges sur ce que les élèves ont vu et compris lors de laudience et pour répondre à leurs questions.
Consulter le programme de la journée.
Premier Cap Métiers Tour en Périgord Vert
Le premier Cap Métiers Tour en Périgord Vert s'est tenu à la Maison des Associations de La Coquille du 27 novembre au 1er décembre.
Le Cap Métier Tour est un forum itinérant qui permet à des collégiens à partir de la 5e, des lycéens de seconde et tous les publics en recherche dinformation sur lorientation et les métiers, de découvrir des métiers, des secteurs dactivités et des formations de manière ludique et interactive au travers de 3 ateliers.
Visite du forum Métiers Emploi Travail
Dans le cadre du Parcours Avenir, les élèves de 3e ont participé à la 4ème édition du forum Métiers Emploi Travail vendredi 10 novembre de 9h à 10h30 au gymnase René Forestier à Thiviers.
Ce forum a pour but de faire découvrir les métiers, formations et savoir-faire existants sur le territoire notamment par le geste. L'objectif des professionnels présents : faire partager la passion de leur métier.
Consulter le livret préparatoire à la visite (secteurs d'activités présents, exemples de questions,...) qui vous a été présenté en classe.
De 11h à 12h, les élèves en ont profité pour visiter le lycée professionnel Porte d'Aquitaine afin de découvrir les formations qui y sont proposées (pôle bois, pôle cuir).
Consulter l'album photos de la journée sur la page facebook de la Communauté de communes Périgord Limousin.
Les 5e dans les Coulisses du Bâtiment
Présentation des métiers des différents corps d'armée
Dans le cadre du Parcours Avenir et de l'orientation, une présentation des différents corps d'armée a eu lieu lundi 9 octobre 2023 de 14h à 15h45 à l'auditorium pour les 70 élèves de 4e et de 3e.
Le Major Régis Aubrée, chef de centre du CIRFA (centre d'information et de recrutement des forces armées, armée de terre) à Périgueux et le Maître principal Frédéric Coubard, chef de bureau au CIRFA de Brive (recrutement de la marine nationale), ont présenté les parcours et métiers de l'armée de terre, de la marine nationale ainsi que de l'armée de l'air et de l'espace. Les élèves ont ainsi pu découvrir la grande diversité des métiers au sein de l'armée, les formations et conditions d'accès ainsi que les compétences requises.
De la documentation a été proposée aux élèves intéressés qui ont pu rester à la fin de l'intervention pour un temps d'échanges/questions. Documentation donnée également pour le CDI et à la disposition de tous.